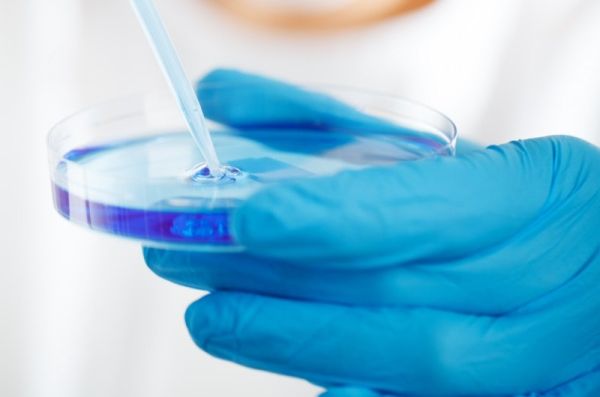
New antibiotic zosurabalpin shows promise against superbug

Researchers discovered that a new type of antibiotic, zosurabalpin, can kill A. baumannii. Photo by Petr Kratochvil/Public Domain Pictures
Researchers report that a new type of antibiotic has proved its mettle against a deadly superbug.
Acinetobacter baumannii, a bacteria goes by the nickname CRAB, can trigger serious infections in the lungs, urinary tract and blood, according to the U.S. Centers for Disease Control and Prevention. Unfortunately, it’s resistant to a class of powerful broad-spectrum antibiotics called carbapenems. Advertisement
Now, in a study published Wednesday in the journal Nature, researchers from Harvard University and the pharmaceutical company Hoffmann-La Roche discovered that a new type of antibiotic, zosurabalpin, can kill A. baumannii.
Zosurabalpin employs a unique method of action, researcher Dr. Kenneth Bradley, global head of infectious disease discovery with Roche Pharma Research and Early Development, told CNN.
“This is a novel approach, both in terms of the compound itself but as well as the mechanism by which it kills bacteria,” he explained. A. baumannii is a Gram-negative bacteria, meaning it is protected by both inner and outer membranes, making it difficult to attack. Advertisement
In this study, the scientists first tried to identify and then fine-tune a molecule that could cross those double membranes and eliminate the bacteria.
After years of improving the potency and safety of a number of compounds, the researchers chose one modified molecule.
How does it work? Zosurabalpin prevents the movement of large molecules called lipopolysaccharides to the outer membrane of the bacteria, where they keep the protective membrane intact. This causes the molecules to accumulate inside the bacteria’s cell to the point where the cell becomes so toxic that it dies.
In the study, zosurabalpin worked against more than 100 CRAB samples. It also reduced the levels of bacteria in mice with CRAB-induced pneumonia and prevented the death of mice with sepsis triggered by the bacteria.
Zosurabalpin is now being tested in phase 1 clinical trials, to assess its safety in humans, the researchers told CNN.
Still, the public health threat of antimicrobial resistance remains a huge problem globally due to a lack of effective treatments, Dr. Michael Lobritz, worldwide leader of infectious diseases at Roche Pharma Research and Early Development, told CNN.
In the United States, there are more than 2.8 million antimicrobial-resistant infections each year. More than 35,000 people die as a result, according to the CDC’s 2019 Antibiotic Resistance Threats Report. Advertisement
Even though zosurabalpin is years away from human use, it’s an extremely promising development, Dr. César de la Fuente, presidential assistant professor at the University of Pennsylvania, told CNN.
“I think from an academic perspective, it is exciting to see a new type of molecule that kills bacteria in a different way,” de la Fuente said. “We certainly need new out-of-the-box ways of thinking about antibiotic discovery, and I think this is a good example of that.”
The only drawback to the discovery is that the modified molecule will work only against the specific bacteria it is designed to kill, the researchers noted.
However, de la Fuente said this new method could turn out to be better than many broad-spectrum antibiotics.
“For decades, we’ve been obsessed with creating or discovering broad-spectrum antibiotics that kill everything,” he noted. “Why not try to come up with specific, more targeted antibiotics that only target the pathogen that is causing the infection and not all the other things that might be good for us?”
Visit the CDC for more on Acinetobacter baumannii.
